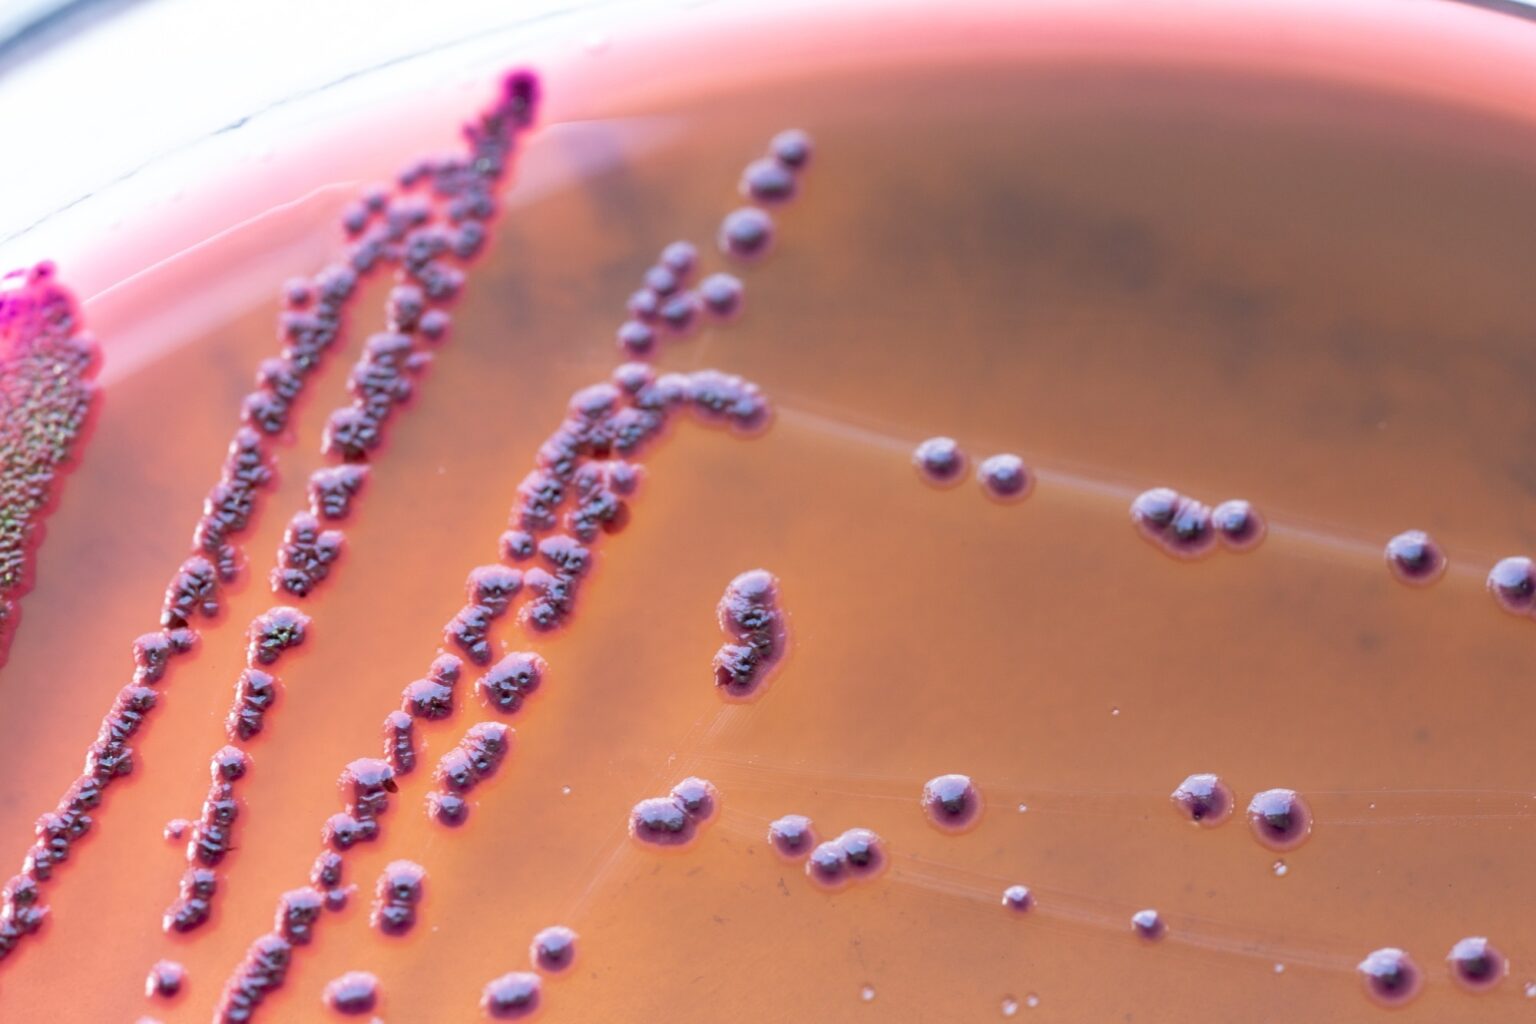

With quercetin as a natural reducer and stabilizer, ZnS quantum dots break down stubborn dyes and disrupt bacterial biofilms, all while remaining safe for healthy cells.
Study: Green synthesis of quercetin-mediated ZnS quantum dots and their photocatalytic, antimicrobial, and cytotoxic performances. Image Credit: Sinhyu Photographer/Shutterstock.com
In a new Scientific Reports study, researchers demonstrate an environmentally friendly method for producing zinc sulfide (ZnS) quantum dots using quercetin, a plant-derived flavonoid that doubles as a reducing and stabilizing agent.
Quantum dots (QDs) exhibit unique optical and electronic behaviors when their dimensions fall below the exciton Bohr radius, approximately 10 nm for ZnS.
These nanoscale properties make ZnS QDs particularly valuable for applications in imaging, sensing, and photocatalysis.
Traditional synthesis techniques typically require high temperatures, specialized equipment, or non-aqueous solvents. In contrast, green syntheses are often simpler, more sustainable routes.
Quercetin, with its polyphenolic structure, provides both the reducing power and surface-stabilizing functionality needed to generate uniform ZnS nanocrystals in water-based systems.
Get all the details: Grab your PDF here!
Synthetic Approach
The team conducted the synthesis in aqueous solution at 70 °C. Zinc nitrate and sodium sulfate were first mixed and heated.
After one hour, quercetin was added dropwise, where it reduced sulfate ions to sulfide and initiated ZnS nucleation.
The resulting quantum dots were isolated in both liquid dispersion and powdered form for characterization.
Optical and Structural Characterization
UV-Vis spectroscopy showed two ZnS absorption features around 370 nm and 298 nm, characteristic of strong quantum confinement.
Photoluminescence analysis revealed emissions at approximately 480, 613, and 645 nm, corresponding to defect- and surface-related states influenced by quercetin capping.
FTIR confirmed quercetin-derived functional groups, including hydroxyl, carboxyl, and aromatic features, anchored to the nanoparticle surface. X-ray diffraction indicated the expected zinc blende crystal phase with crystallite sizes between four and eight nanometers.
SEM images revealed nanoscale aggregates, while TEM confirmed well-dispersed, largely spherical particles under 10 nm. EDX analysis verified the presence of Zn and S alone, supporting high purity.
Thermal and Photoluminescence Stability
Temperature-dependent PL measurements conducted from 0 to 40 °C showed predictable decreases in intensity at higher temperatures due to phonon-assisted nonradiative processes.
Importantly, PL intensity recovered fully across multiple heating–cooling cycles, indicating strong structural stability, an essential requirement for biomedical imaging applications near physiological temperatures.
Biofilm and Antimicrobial Performance
Biofilm inhibition assays demonstrated substantial activity against Pseudomonas aeruginosa and Escherichia coli, with reductions of approximately 84 % and 83 %, respectively.
This biofilm-targeted action is especially important for combating surface-associated infections, which are often resistant to conventional treatments.
In antifungal tests against Candida albicans, the ZnS QDs produced a 22 mm inhibition zone, outperforming a standard chlorhexidine control (20 mm).
These effects are attributed to reactive oxygen species generation, ion release, and surface interactions that disrupt microbial structures.
An MTT assay on L929 fibroblast cells showed that viability remained above 75 % across all tested concentrations, indicating promising biocompatibility for biomedical use. The modest viability reduction reflects expected nanoparticle-cell interactions without significant cytotoxicity.
Photocatalytic Dye Degradation
Under UV irradiation for 24 hours, the quantum dots degraded brilliant green dye by about 85 % and methylene blue by roughly 70 %.
These results stem from efficient electron-hole generation and ROS formation on the ZnS surface, which accelerates dye breakdown.
Higher QD concentrations further increased degradation rates, aligning with first-order Langmuir-Hinshelwood kinetics.
Conclusion
Overall, the study presents a sustainable, quercetin-mediated route to producing ZnS quantum dots with well-defined optical, structural, antimicrobial, and photocatalytic characteristics.
Their combination of biofilm inhibition, thermal stability, biocompatibility, and strong dye degradation positions them as promising candidates for future biomedical and environmental applications.
Journal Reference
Sensoy Gün B., et al. (2025). Green synthesis of quercetin-mediated ZnS quantum dots and their photocatalytic, antimicrobial, and cytotoxic performances. Sci Reports. DOI:https://doi.org/10.1038/s41598-025-29362-y